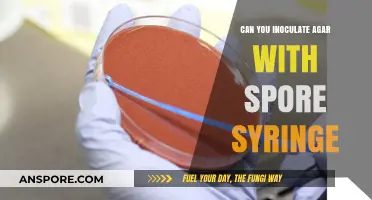
Inoculating Agar with Spore Syringes: A Step-by-Step Guide

Inoculating grain with spores is a technique used in various agricultural and fermentation processes, particularly in the production of foods like tempeh, miso, and certain types of beer. This method involves introducing specific fungal or bacterial spores, such as those from *Rhizopus oligosporus* or *Aspergillus oryzae*, to grains like rice, barley, or soybeans. The spores colonize the grain, breaking down complex carbohydrates and proteins into simpler compounds, which enhances flavor, texture, and nutritional value. Proper inoculation requires precise control of moisture, temperature, and spore concentration to ensure successful colonization and prevent contamination. This practice is not only essential for traditional food production but also holds potential for sustainable agriculture and bio-based industries.
| Characteristics | Values |
|---|---|
| Process | Inoculating grain with spores involves introducing beneficial microorganisms (e.g., bacteria, fungi) to grain substrates to promote fermentation, enhance nutrient content, or produce specific compounds like enzymes or bioactive substances. |
| Common Spores Used | Lactic acid bacteria (LAB), Bacillus subtilis, Aspergillus oryzae, Rhizopus oligosporus, and other fungi or bacteria depending on the desired outcome. |
| Purpose | Fermentation (e.g., tempeh, miso, sourdough), bioaugmentation (improving soil health), or production of enzymes, probiotics, or bioactive compounds. |
| Grain Types | Commonly used grains include rice, wheat, barley, millet, sorghum, and maize, depending on the application. |
| Inoculation Method | Spores are mixed with sterilized or pre-treated grain, often in controlled conditions (temperature, humidity) to ensure spore germination and growth. |
| Benefits | Enhances nutritional value, improves digestibility, preserves grain, and produces unique flavors or textures in fermented products. |
| Challenges | Requires precise control of environmental conditions, risk of contamination by unwanted microorganisms, and variability in spore viability. |
| Applications | Food fermentation (tempeh, miso, sourdough), animal feed enhancement, biofuel production, and environmental bioremediation. |
| Research Status | Active research in optimizing spore strains, inoculation techniques, and understanding microbial interactions for improved outcomes. |
| Commercial Use | Widely used in traditional and industrial fermentation processes, as well as in agricultural and biotechnological applications. |
Explore related products
What You'll Learn
- Spores Selection: Choosing suitable spore strains for grain inoculation based on desired fermentation outcomes
- Inoculation Techniques: Methods for evenly distributing spores on grain for consistent fermentation results
- Grain Preparation: Cleaning, soaking, and sterilizing grain to create an optimal environment for spore growth
- Fermentation Control: Monitoring temperature, humidity, and pH to ensure successful spore colonization of grain
- Post-Inoculation Care: Proper storage and handling of inoculated grain to maintain spore viability

Spores Selection: Choosing suitable spore strains for grain inoculation based on desired fermentation outcomes
Selecting the right spore strains for grain inoculation is pivotal to achieving the desired fermentation outcomes. Different spore strains, particularly from fungi like *Aspergillus*, *Rhizopus*, or *Bacillus*, produce distinct metabolic byproducts that influence flavor, aroma, and texture. For instance, *Aspergillus oryzae* is commonly used in sake production to break down starches into fermentable sugars, while *Rhizopus oligosporus* is favored in tempeh for its ability to bind soybeans into a firm cake. Understanding the specific role of each strain ensures that the inoculation aligns with the intended product, whether it’s a beverage, baked good, or fermented food.
When choosing spore strains, consider the fermentation environment and desired sensory profile. For example, *Bacillus subtilis* thrives in high-temperature fermentations, making it suitable for African sorghum beers, while *Aspergillus niger* excels in low-pH environments, ideal for certain vinegar productions. Dosage is equally critical; a general rule is to use 1–5% spore inoculum by weight of grain, but this varies based on strain and substrate. Over-inoculation can lead to off-flavors or incomplete fermentation, while under-inoculation may result in slow or inconsistent results. Always test small batches to calibrate the optimal dosage for your specific grain and conditions.
Comparing spore strains reveals their unique advantages and limitations. For instance, *Aspergillus kawachii* produces higher levels of amylase, accelerating starch breakdown, but it may overpower delicate flavors in certain applications. In contrast, *Rhizopus microsporus* offers rapid fermentation but requires careful monitoring to prevent over-acidification. Strains like *Bacillus amyloliquefaciens* are prized for their ability to enhance shelf life by producing antimicrobial compounds, making them ideal for long-term storage products. Evaluating these trade-offs ensures the chosen strain complements the grain’s natural properties and the desired end product.
Practical tips for spore selection include sourcing strains from reputable suppliers to ensure purity and viability. Store spores in a cool, dry place, and rehydrate them according to the supplier’s instructions before inoculation. For mixed-culture fermentations, introduce strains sequentially to control their interactions; for example, start with amylolytic strains to break down starches before adding acid-tolerant strains. Regularly monitor pH, temperature, and sensory changes during fermentation to adjust conditions as needed. With careful selection and management, spore inoculation can transform grain into a diverse array of fermented products, each with its unique character.
Are Spores Metabolically Active? Unraveling the Dormant Life Cycle Mystery
You may want to see also

Inoculation Techniques: Methods for evenly distributing spores on grain for consistent fermentation results
Achieving uniform spore distribution on grain is critical for consistent fermentation outcomes, whether in brewing, distilling, or composting. Uneven inoculation can lead to patchy fermentation, off-flavors, or incomplete substrate colonization. The key lies in selecting the right technique for your spore type, grain moisture content, and desired fermentation scale.
Dry Mixing: Simplicity with Limitations
For small-scale applications or amateur brewers, dry mixing offers a straightforward approach. This involves blending spore powder directly with dry grain, relying on mechanical agitation to achieve distribution. While simple, this method suffers from inherent limitations. Spore clumping and static electricity can lead to uneven dispersal, particularly with fine spore powders. Additionally, dry mixing is unsuitable for high-moisture grains, as clumping worsens with increased humidity.
Liquid Suspension: Precision and Control
A more precise method involves creating a spore suspension in sterile water or a nutrient solution. This liquid is then sprayed or gently poured over the grain, ensuring a more even coating. This technique allows for better control over spore dosage, typically ranging from 1-5 grams of spores per kilogram of grain, depending on the desired fermentation intensity. For optimal results, the grain should be pre-moistened to a specific moisture content (around 50-60% for most fermentations) to facilitate spore adhesion.
Misting and Atomization: Fine-Tuning Distribution
For industrial-scale operations or those seeking the highest level of uniformity, misting or atomization techniques are employed. These methods utilize specialized equipment to generate a fine spore mist, which is then evenly distributed over the grain surface. This approach minimizes clumping and ensures a consistent spore density across the entire substrate. However, it requires specialized equipment and careful calibration to avoid over-saturation or spore loss due to drift.
Considerations for Success
Regardless of the chosen method, several factors influence inoculation success. Grain temperature should be optimal for spore germination, typically around 25-30°C (77-86°F). Sterilization of equipment and grain is crucial to prevent contamination by competing microorganisms. Finally, proper aeration during the initial stages of fermentation promotes spore germination and mycelium growth, leading to a more robust and consistent fermentation process.
Understanding Spores: Nature's Ingenious Method for Reproduction and Survival
You may want to see also

Grain Preparation: Cleaning, soaking, and sterilizing grain to create an optimal environment for spore growth
Grain preparation is a critical step in inoculating grain with spores, as it directly influences the success of spore colonization. The process begins with cleaning, which removes debris, dust, and potential contaminants that could hinder spore growth or introduce unwanted microorganisms. Use a fine-mesh strainer or sieve to rinse the grain thoroughly under cool, running water, ensuring all particles are washed away. This step is particularly vital for grains like rye or wheat, which often carry more surface impurities compared to cleaner options like millet or sorghum.
Once cleaned, soaking the grain hydrates it, preparing the substrate for spore inoculation. Soaking times vary by grain type: rye typically requires 12–24 hours, while harder grains like wheat may need up to 48 hours. A general rule is to soak until the grain swells to about 1.5 times its original size. Water temperature matters—use cool water (18–22°C) to prevent premature germination or mold growth. Discard any grains that float, as they are unlikely to absorb enough moisture for optimal spore development.
Sterilization is the final and most crucial step, creating a sterile environment that favors the target spores while eliminating competitors. Boiling the soaked grain for 10–15 minutes is a common method, but pressure cooking is more reliable. Use a pressure cooker at 15 psi for 45–60 minutes to ensure all contaminants are eradicated. Allow the grain to cool to 25–30°C before inoculation—spores are sensitive to heat, and temperatures above 35°C can kill them. Proper sterilization not only ensures spore viability but also prevents contamination from bacteria or wild fungi, which can outcompete the desired spores.
A comparative analysis of sterilization methods reveals that pressure cooking yields higher success rates than boiling, particularly for large batches. Boiling may leave pockets of contamination, while pressure cooking penetrates the grain more thoroughly. However, boiling is simpler and sufficient for small-scale projects. For those using a pressure cooker, ensure the release valve is functioning properly to avoid overcooking or undercooking the grain.
In conclusion, meticulous cleaning, precise soaking, and effective sterilization are non-negotiable steps in preparing grain for spore inoculation. Each stage serves a distinct purpose, from removing physical barriers to creating a sterile, nutrient-rich environment. By adhering to these practices, cultivators can maximize spore colonization rates and minimize the risk of contamination, setting the stage for successful grain-based mycelium cultivation.
Windblown Spores: A Land-Based Reproductive Adaptation Strategy Explored
You may want to see also
Explore related products

Fermentation Control: Monitoring temperature, humidity, and pH to ensure successful spore colonization of grain
Successful spore colonization of grain hinges on creating an environment where beneficial microorganisms thrive. Temperature, humidity, and pH are the trifecta of factors dictating whether your inoculation efforts flourish or fail. Think of them as the dials on a complex instrument, each requiring precise adjustment for harmonious fermentation.
Temperatures between 28°C and 35°C (82°F and 95°F) are the sweet spot for most spore-based fermentations. This range mimics the natural conditions favored by many fungi and bacteria, encouraging rapid germination and metabolic activity. Deviations below 25°C can slow colonization, while exceeding 37°C risks killing the spores altogether.
Humidity is equally critical, as spores require moisture to activate and penetrate the grain matrix. Aim for a relative humidity of 70-80% within your fermentation vessel. This level ensures the grain remains damp enough for spore mobility without becoming waterlogged, which can lead to mold or spoilage. Regular misting or using a humidifier can help maintain this delicate balance.
PH plays a subtle yet vital role in spore colonization. Most beneficial fungi and bacteria prefer a slightly acidic environment, with an optimal pH range of 4.5 to 6.0. This acidity discourages competing microorganisms while promoting the growth of your desired spores. Adjusting pH can be achieved through the addition of small amounts of food-grade acids like citric or lactic acid, but exercise caution – drastic changes can harm the spores.
Regular monitoring is paramount. Invest in reliable thermometers, hygrometers, and pH meters to track these parameters throughout the fermentation process. Data logging devices can provide valuable insights into trends and fluctuations, allowing for proactive adjustments. Remember, consistency is key – sudden shifts in temperature, humidity, or pH can stress the spores and derail your fermentation.
By meticulously controlling these environmental factors, you create a sanctuary for your inoculated spores, fostering their growth and ensuring a successful and flavorful fermentation.
Can Spor Flip Flops Lead to Achilles Tendonitis? Find Out
You may want to see also

Post-Inoculation Care: Proper storage and handling of inoculated grain to maintain spore viability
Inoculating grain with spores is a precise process, but the real challenge begins after inoculation. Proper post-inoculation care is critical to maintaining spore viability, ensuring the success of your fermentation or cultivation project. The delicate balance of moisture, temperature, and oxygen levels can make or break the outcome. For instance, spores of *Aspergillus oryzae*, commonly used in koji production, require a humidity level of 90-95% and a temperature range of 28-32°C (82-90°F) to thrive. Deviating from these conditions can lead to spore dormancy or contamination.
Steps for Optimal Storage: Begin by transferring inoculated grain to a sterile, breathable container, such as a food-grade plastic tray with perforated lids. This allows for adequate air exchange while minimizing contamination risk. Maintain a consistent temperature within the specified range for your spore type, using heating pads or incubators as needed. For example, *Rhizopus oligosporus*, used in tempeh production, prefers 30-35°C (86-95°F). Monitor humidity levels daily, misting the grain lightly with sterile water if levels drop below 90%. Avoid over-misting, as excess moisture can promote mold growth.
Cautions to Consider: Rapid temperature fluctuations or exposure to direct sunlight can stress spores, reducing their viability. Store inoculated grain away from windows or heat sources, and avoid stacking containers to ensure proper air circulation. Additionally, refrain from handling the grain with bare hands; use sterile gloves or tools to prevent introducing foreign microorganisms. If using a refrigerator for short-term storage (e.g., 24-48 hours), ensure the temperature does not drop below 4°C (39°F), as this can shock the spores.
Practical Tips for Success: Label containers with the inoculation date, spore type, and target incubation duration to track progress. For long-term storage (up to 2 weeks), consider using vacuum-sealed bags with oxygen absorbers to create an anaerobic environment, which can extend spore viability. Periodically inspect the grain for signs of contamination, such as off-colors or unusual odors. If detected, isolate the affected batch immediately to prevent cross-contamination.
Fitting a Picnic Table in a Jeep Sport: Tips and Tricks
You may want to see also
Frequently asked questions
Yes, grain can be inoculated with spores, particularly those of fungi like *Aspergillus*, *Penicillium*, or *Rhizopus*, for processes such as fermentation, malting, or producing specific flavors and compounds.
Commonly used spores include those from *Aspergillus oryzae* (for koji production), *Rhizopus oligosporus* (for tempeh), and *Penicillium roqueforti* (for blue cheese), depending on the desired outcome.
Grain is typically inoculated by mixing the spores (in liquid or powder form) evenly with the grain, ensuring proper moisture and temperature conditions to allow the spores to germinate and grow.
Inoculating grain with spores can enhance flavor, improve nutrient availability, facilitate fermentation, and produce specific enzymes or metabolites, depending on the application.